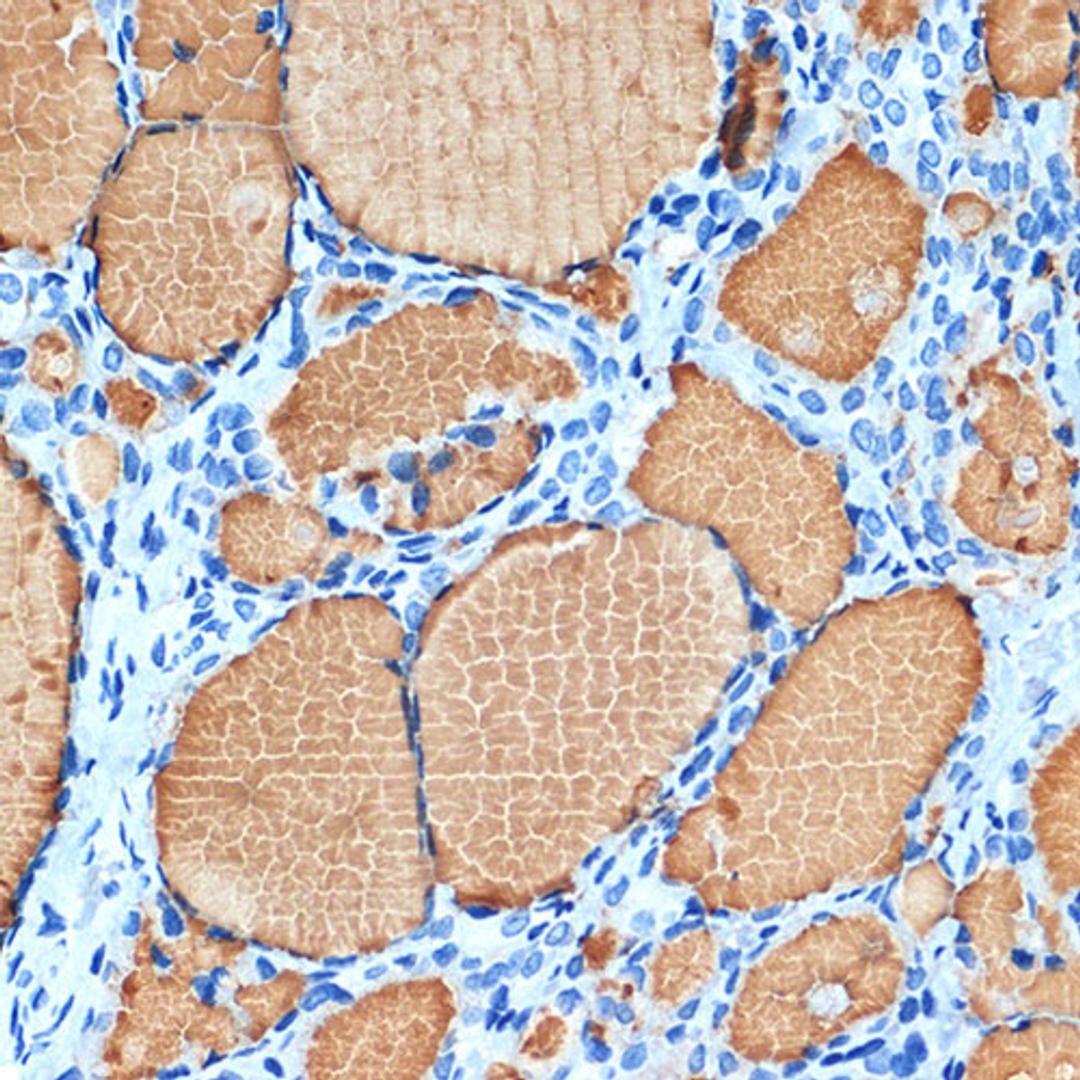
Immunohistochemistry - Thyroglobulin Rabbit mAb (A3407)

Thyroglobulin Rabbit mAb
Product Details
- Cat. No.
- A3407
- Type
- Primary Antibody
- Clonality
- Monoclonal
- Host
- Rabbit

The supplier does not provide quotations for this antibody through SelectScience. You can search for similar antibodies in our Antibody Directory.
Description
Thyroglobulin (Tg) is a glycoprotein homodimer produced predominantly by the thryroid gland. It acts as a substrate for the synthesis of thyroxine and triiodothyronine as well as the storage of the inactive forms of thyroid hormone and iodine. Thyroglobulin is secreted from the endoplasmic reticulum to its site of iodination, and subsequent thyroxine biosynthesis, in the follicular lumen. Mutations in this gene cause thyroid dyshormonogenesis, manifested as goiter, and are associated with moderate to severe congenital hypothyroidism. Polymorphisms in this gene are associated with susceptibility to autoimmune thyroid diseases (AITD) such as Graves disease and Hashimoto thryoiditis. [provided by RefSeq, Nov 2009]
Biological Information
- Clonality: Monoclonal
- Host: Rabbit
- Reactivity: Human, Mouse, Rat